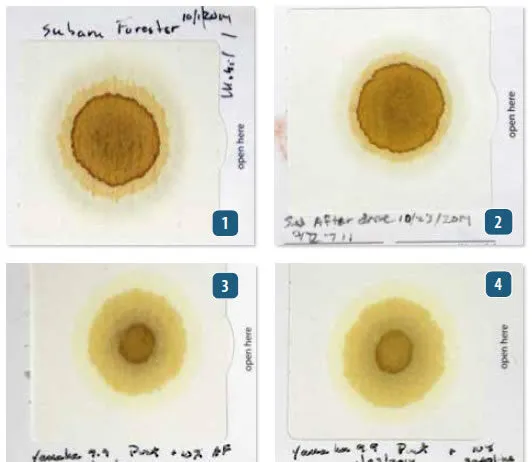
DIY Engine Oil Tests Blotter test patterns reveal engine condition: clean oil shows defined rings, while coolant contamination shrinks the center circle by clogging pores. Fuel dilution may not create obvious visual changes—in some cases, smell is the primary indicator—making successive comparisons essential for spotting subtle shifts in engine health. See more detailed info about these tests at the end of the article. (Photo/ Drew Frye)

Testing Boat Fuel Stability in Diesel and Gasoline
We followed standard test methods for storage stability. Diesel was tested using ASTM method D 4625, Standard Test Method for Middle Distillate Fuel Storage Stability at 43C. Samples were exposed to air for up to two years at 113 degrees (45 degrees Celsius); each day simulated about four days of real-world storage, according to industry experience. We settled on 8 months of exposure, the equivalent of about three years. At the end of each period, samples were filtered, and the insoluble solids weighed.
Reduce Gasoline Evaporation in Boats with These Tips
Sometimes it is not what has been added to your fuel that matters, but what is missing. The most obvious difference between gasoline and diesel during our vented, fuel-aging tests was that gasoline samples evaporated and required replenishment at the mid-way point; diesel samples did not. Studies by BoatUS and the U.S. Environmental Protection Agency (EPA) have shown that anywhere between 5 and 20 percent of the contents of a portable or installed polyethylene gas tank can vanish in one year through evaporation and permeation. The remaining fuel is lower in octane, contains fewer of the volatiles that are so essential for easy starting, and has reduced solvency for gum and varnish. It often looks perfectly good-most of our samples did-but it is perfectly rotten and potentially harmful as fuel.
Coolants that Fight Corrosion
Salt and water conspire to reduce our boats, our pride and joys, to pitted and unreliable money pits. Weve investigated corrosion of wiring (see PS July 2010 online), gasoline (see PS August 2012 online), diesel (see PS August 2013 online), and winterizing fluids (see PS September 2014 online), uncovering additives and practices that dramatically reduce deterioration and increase reliability. Engine cooling systems have similar vulnerabilities, and fortunately for us, the automotive engine manufacturers have invested millions in finding those solutions. However, the marketing materials don't always make the differences clear, and its hard to know which product is the best for your engine.
ASTM D1384 Serves as Model for Testers
Samples were tested for corrosion protection following the ASTM D1384 Corrosion in Glassware method (www.astm.org). Samples were diluted to 33-percent glycol, dosed with ASTM synthetic corrosive water (similar to 2-percent seawater), continuously aerated, and heated to 190 degrees for two weeks. As a laboratory control, a reference coolant (ASTM D 3585) was also exposed to provide a baseline.
Test Checks Burst Point and Freeze Protection
We tested each product for glycol content using a refractometer and either the ethylene glycol or propylene glycol scale, as appropriate. In the case of Camcos Arctic Ban and Sudburys Winter Stor, some portion of the freeze protection is provided by ethanol, and such mixtures cannot be easily evaluated by any field method (test tape, gravity, refractometer) unless the exact proportion is known, which we find troublesome.
Refractometer Takes Out All the Guesswork
What matters most, our testing confirms, is not so much which brand of pink stuff you choose, but how you use it. Even the best product, mixed with too much water left in the line, results in a blend with unknown and perhaps unsatisfactory performance. While this may not be critical in North Carolina, sailors in Wisconsin need to get it right.
Step-by-step Winterizing Tips
Winterizing agents should never be used in freshwater tanks or hot-water tanks. Doing so will greatly increase the chances of biological growth, which can result in foul-smelling, bad-tasting water. If your boats water system does not have bypass fittings that allow you to add glycol to waterlines, install them. The addition of a few simple fittings can reduce the annual process from hours to minutes for the cost of a few jugs of glycol.
PSs Top Picks for Winterizing
Protecting marine water systems from freeze damage is a deceptively simple goal. The terminology and various product claims can be confusing, and what seems like a good common-sense decision can lead to trouble. We tend to think that all water systems are the same; that boats as well as RVs can be protected by the same pink antifreeze without any further thought. However, many of the problems we associate with age, or normal wear and tear-stiff impellers, cracked pipes, ruined joker valves, and foul-tasting tap water-can often be attributed to errors during winterization.
Summer Sailing Gear
Summers warm breezes and lazy weekends have arrived, so PS testers have put together a lineup of cool toys and tools for the dog days. Tower Adventurer Inflatable Standup Paddleboard: Inflatable SUPs are sprouting up everywhere on the Internet; many boards are identical, made by different brands at the same factories in China. Quality varies. Generally, boards 6 inches or thicker offer better stiffness and stability, making them easier to ride.
Propane-powered Propulsion
Capt. Bernardo Herzer has been converting small engines from conventional fuels to propane since he was a teenager. In 2012, he introduced his first propane outboards, 2.5 horsepower, 5-horsepower, and 9.9-horsepower models. Practical Sailor recently tested the 5-hp Lehr LP 5.0, a water-cooled four-stroke with an electric ignition-no priming or choke required. It operates at 4,000 to 4,500 rpm at wide open throttle, and the 49.6-pound, short-shaft model pushed our 120-pound test boat at 11-12 knots. The engine can be fueled using a 16.4-ounce propane twist-on bottle like those used with camping stoves or a 5-gallon, 20-pound remote propane tank.